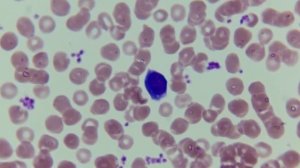

2:03
2:03
2024-08-13 09:23

 9:55
9:55

 9:55
9:55
2025-09-02 06:00

 12:10
12:10

 12:10
12:10
2025-07-28 05:55

 5:44
5:44

 5:44
5:44
2024-04-25 13:15

 9:00
9:00

 9:00
9:00
2025-09-01 12:00

 11:38
11:38

 11:38
11:38
2023-11-14 17:47

 2:44
2:44
2:44
2:44
2024-01-18 06:21

 3:05
3:05

 3:05
3:05
2024-04-25 21:27

 28:02
28:02

 28:02
28:02
2025-02-04 05:46

 9:11
9:11

 9:11
9:11
2025-08-18 15:00

 16:08
16:08

 16:08
16:08
2024-08-28 21:36

 29:12
29:12

 29:12
29:12
2022-03-26 22:18

 1:19
1:19

 1:19
1:19
2022-03-16 10:35

 1:58
1:58

 1:58
1:58
2025-09-24 17:00

 5:22
5:22

 5:22
5:22
2022-04-26 11:09

 9:05
9:05

 9:05
9:05
2025-09-19 10:00

 56:08
56:08

 56:08
56:08
2024-10-29 13:30

 3:36
3:36
![MARSO - Дура (Премьера клипа 2025)]() 3:05
3:05
![Рейсан Магомедкеримов, Ренат Омаров - Бла-та-та (Премьера клипа 2025)]() 2:26
2:26
![Артур Пирожков - ALARM (Премьера клипа 2025)]() 3:22
3:22
![Владимир Ждамиров - Чифирок (Премьера клипа 2025)]() 3:49
3:49
![Динара Швец - Новая история (Премьера клипа 2025)]() 3:45
3:45
![Зара - Я несла свою беду (Премьера клипа 2025)]() 3:36
3:36
![Magas - Без тебя (Премьера клипа 2025)]() 2:28
2:28
![Ислам Итляшев - Скандал (Премьера клипа 2025)]() 2:08
2:08
![INSTASAMKA - BOSS (Премьера клипа 2025)]() 3:41
3:41
![Женя Белоусова - Кто тебе сказал (Премьера клипа 2025)]() 3:27
3:27
![Зафар Эргашов - Мусофирда каридим (Премьера клипа 2025)]() 4:58
4:58
![Олег Семенов - Бархатный сезон (Премьера клипа 2025)]() 3:51
3:51
![Сарвар Азим - Бахтим (Премьера клипа 2025)]() 4:10
4:10
![ИЮЛА - Ты был прав (Премьера клипа 2025)]() 2:21
2:21
![Анна Бершадская - Новая я (Премьера клипа 2025)]() 2:41
2:41
![Наталья Влади - А я такая (Премьера клипа 2025)]() 2:21
2:21
![TASSO - Таю (Премьера клипа 2025)]() 3:23
3:23
![INSTASAMKA - AGENT GIRL (Премьера клипа 2025)]() 3:24
3:24
![Игорь Кибирев - Пьяная ночь (Премьера клипа 2025)]() 3:08
3:08
![5sta Family - Антидот (Премьера клипа 2025)]() 3:33
3:33
![Электрический штат | The Electric State (2025)]() 2:08:34
2:08:34
![Дроп | Drop (2025)]() 1:35:31
1:35:31
![Белоснежка | Snow White (2025)]() 1:51:27
1:51:27
![Актер | The Actor (2025)]() 1:38:13
1:38:13
![F1 (2025)]() 2:35:53
2:35:53
![Как приручить дракона | How to Train Your Dragon (2025)]() 2:05:23
2:05:23
![Откровения | Revelations (2025)]() 2:02:28
2:02:28
![Соник 3 в кино | Sonic the Hedgehog 3 (2024)]() 1:50:21
1:50:21
![Счастливчик Гилмор 2 | Happy Gilmore (2025)]() 1:57:36
1:57:36
![Богомол | Samagwi (2025)]() 1:53:29
1:53:29
![Французский любовник | French Lover (2025)]() 2:02:20
2:02:20
![Улица Страха: Королева выпускного | Fear Street: Prom Queen (2025)]() 1:30:05
1:30:05
![Пойман с поличным | Caught Stealing (2025)]() 1:46:45
1:46:45
![Обитель | The Home (2025)]() 1:34:43
1:34:43
![Только ты | All of You (2025)]() 1:38:22
1:38:22
![Финикийская схема | The Phoenician Scheme (2025)]() 1:41:27
1:41:27
![Углубление (2025)]() 2:07:52
2:07:52
![Школьный автобус | The Lost Bus (2025)]() 2:09:55
2:09:55
![Путь рыцаря | A Knight's War (2025)]() 1:43:53
1:43:53
![Вне юрисдикции | Exterritorial (2025)]() 1:49:09
1:49:09
![Пип и Альба. Приключения в Соленой Бухте! Сезон 1]() 11:02
11:02
![Люк - путешественник во времени]() 1:19:50
1:19:50
![Корги по имени Моко. Защитники планеты]() 4:33
4:33
![Отважные мишки]() 13:00
13:00
![Панда и Антилопа]() 12:08
12:08
![Синдбад и семь галактик Сезон 1]() 10:23
10:23
![Игрушечный полицейский Сезон 1]() 7:19
7:19
![Артур и дети круглого стола]() 11:22
11:22
![Агент 203]() 21:08
21:08
![Роботы-пожарные]() 12:31
12:31
![Рэй и пожарный патруль Сезон 1]() 13:27
13:27
![Новое ПРОСТОКВАШИНО]() 6:30
6:30
![Тёплая анимация | Новая авторская анимация Союзмультфильма]() 10:21
10:21
![Поймай Тинипин! Королевство эмоций]() 12:24
12:24
![Псэмми. Пять детей и волшебство Сезон 1]() 12:17
12:17
![Полли Покет Сезон 1]() 21:30
21:30
![Истории Баданаму Сезон 1]() 10:02
10:02
![Крутиксы]() 11:00
11:00
![Простоквашино]() 6:48
6:48
![Приключения Пети и Волка]() 11:00
11:00

 3:36
3:36Скачать видео
| 432x232 | ||
| 640x360 | ||
| 856x480 | ||
| 1280x720 |
 3:05
3:05
2025-10-17 11:37
 2:26
2:26
2025-10-22 14:10
 3:22
3:22
2025-10-20 14:44
 3:49
3:49
2025-10-16 10:37
 3:45
3:45
2025-10-15 10:45
 3:36
3:36
2025-10-18 10:07
 2:28
2:28
2025-10-17 12:00
 2:08
2:08
2025-10-14 10:40
 3:41
3:41
2025-10-23 13:04
 3:27
3:27
2025-10-16 11:15
 4:58
4:58
2025-10-18 10:31
 3:51
3:51
2025-10-16 10:57
 4:10
4:10
2025-10-11 12:49
 2:21
2:21
2025-10-18 10:16
 2:41
2:41
2025-10-22 14:02
 2:21
2:21
2025-10-14 11:07
 3:23
3:23
2025-10-16 10:00
 3:24
3:24
2025-10-17 11:33
 3:08
3:08
2025-10-16 11:32
 3:33
3:33
2025-10-22 13:57
0/0
 2:08:34
2:08:34
2025-03-21 19:58
 1:35:31
1:35:31
2025-05-08 13:13
 1:51:27
1:51:27
2025-06-25 22:36
 1:38:13
1:38:13
2025-04-09 20:04
 2:35:53
2:35:53
2025-08-26 11:45
 2:05:23
2:05:23
2025-07-18 18:28
 2:02:28
2:02:28
2025-04-25 00:41
 1:50:21
1:50:21
2025-01-23 19:58
 1:57:36
1:57:36
2025-08-21 17:43
 1:53:29
1:53:29
2025-10-01 12:06
 2:02:20
2:02:20
2025-10-01 12:06
 1:30:05
1:30:05
2025-06-16 20:00
 1:46:45
1:46:45
2025-10-02 20:45
 1:34:43
1:34:43
2025-09-09 12:49
 1:38:22
1:38:22
2025-10-01 12:16
 1:41:27
1:41:27
2025-06-30 07:40
 2:07:52
2:07:52
2025-02-18 18:05
 2:09:55
2:09:55
2025-10-05 00:32
 1:43:53
1:43:53
2025-07-16 20:59
 1:49:09
1:49:09
2025-08-13 10:53
0/0
2021-09-22 23:36
 1:19:50
1:19:50
2024-12-17 16:00
 4:33
4:33
2024-12-17 16:56
 13:00
13:00
2024-11-29 13:39
 12:08
12:08
2025-06-10 14:59
2021-09-22 23:09
2021-09-22 21:03
 11:22
11:22
2023-05-11 14:51
 21:08
21:08
2025-01-09 16:39
2021-09-23 00:12
2021-09-22 23:51
 6:30
6:30
2018-04-03 10:35
 10:21
10:21
2025-09-11 10:05
 12:24
12:24
2024-11-27 13:24
2021-09-22 22:23
2021-09-22 23:09
2021-09-22 21:29
 11:00
11:00
2022-07-25 18:59
 6:48
6:48
2025-10-17 10:00
 11:00
11:00
2022-04-01 17:59
0/0

